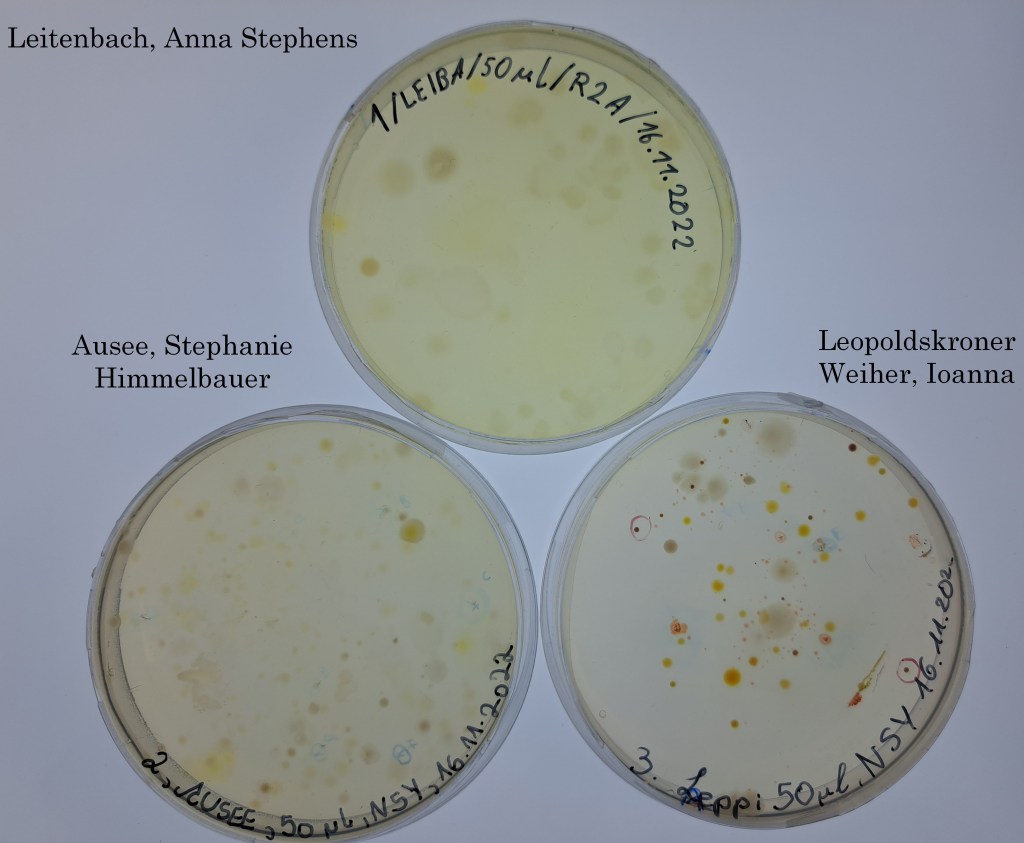
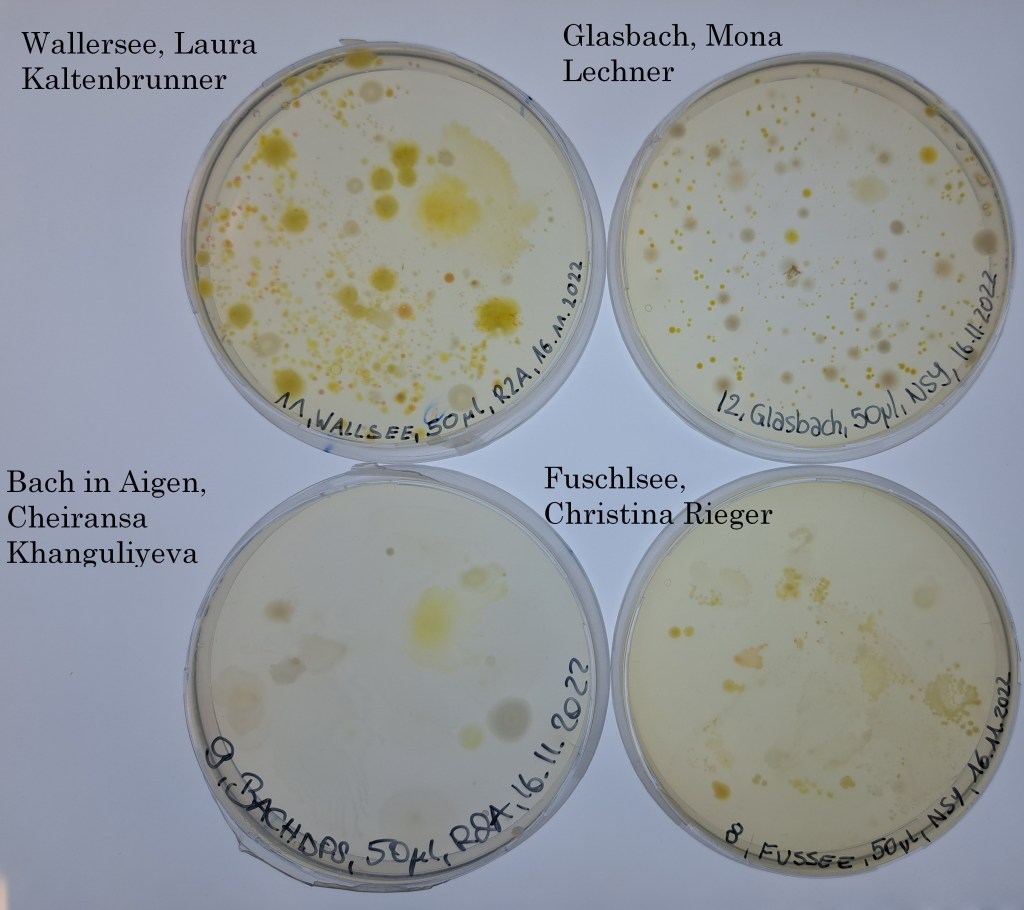
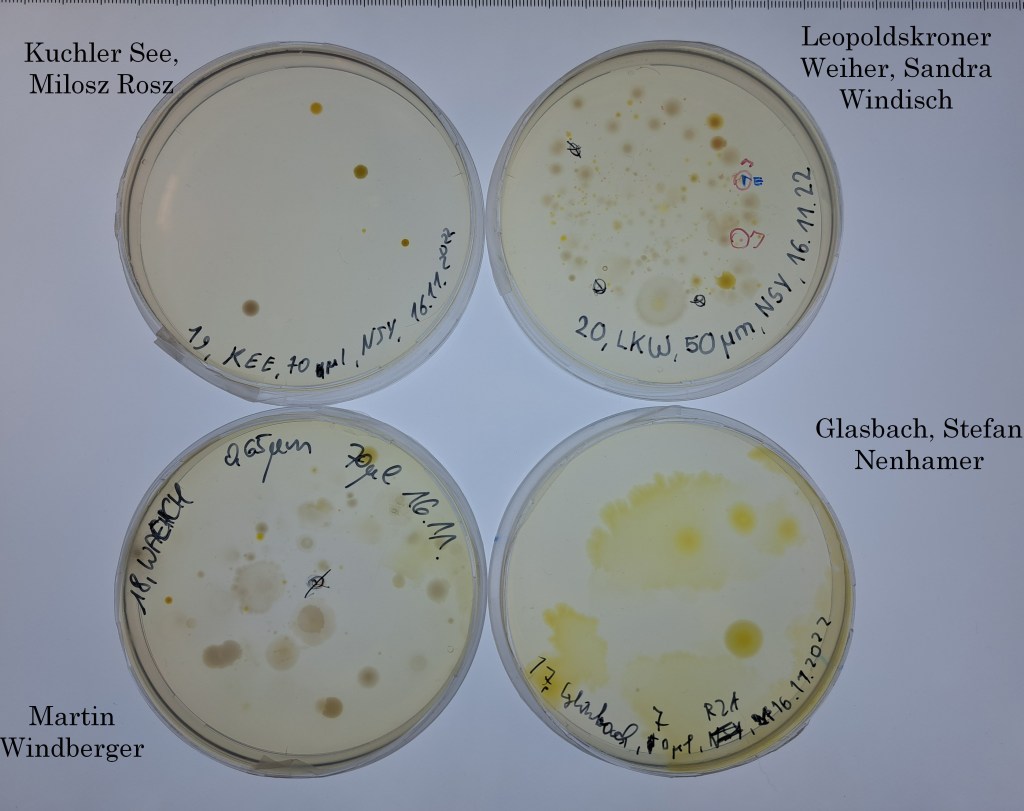
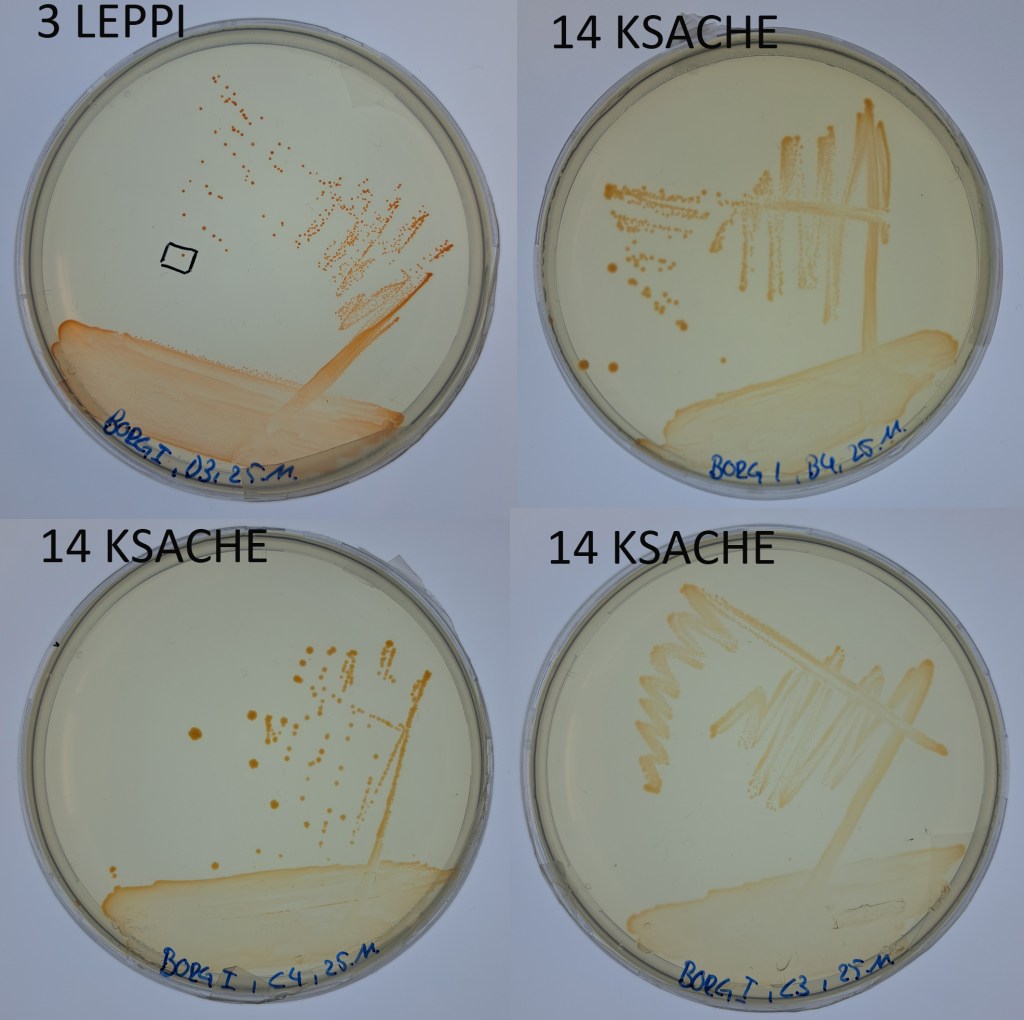
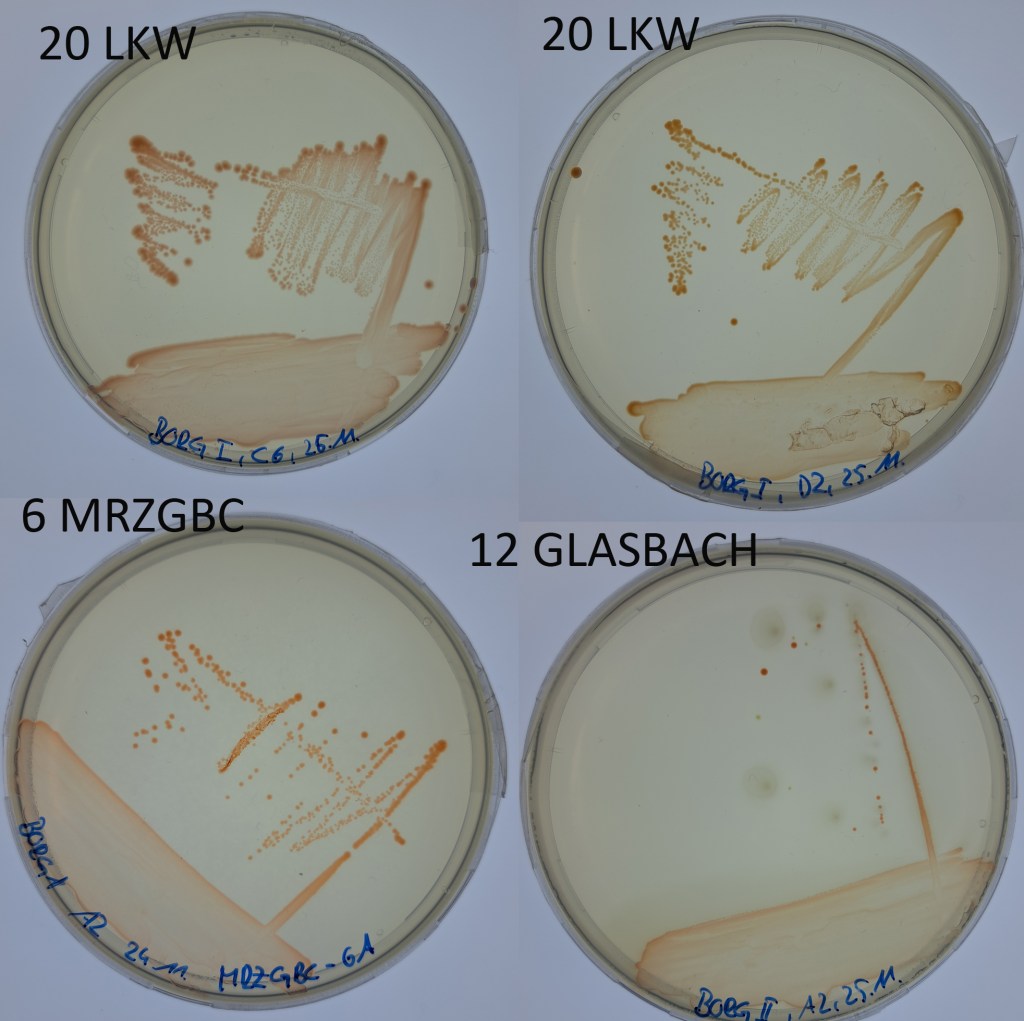
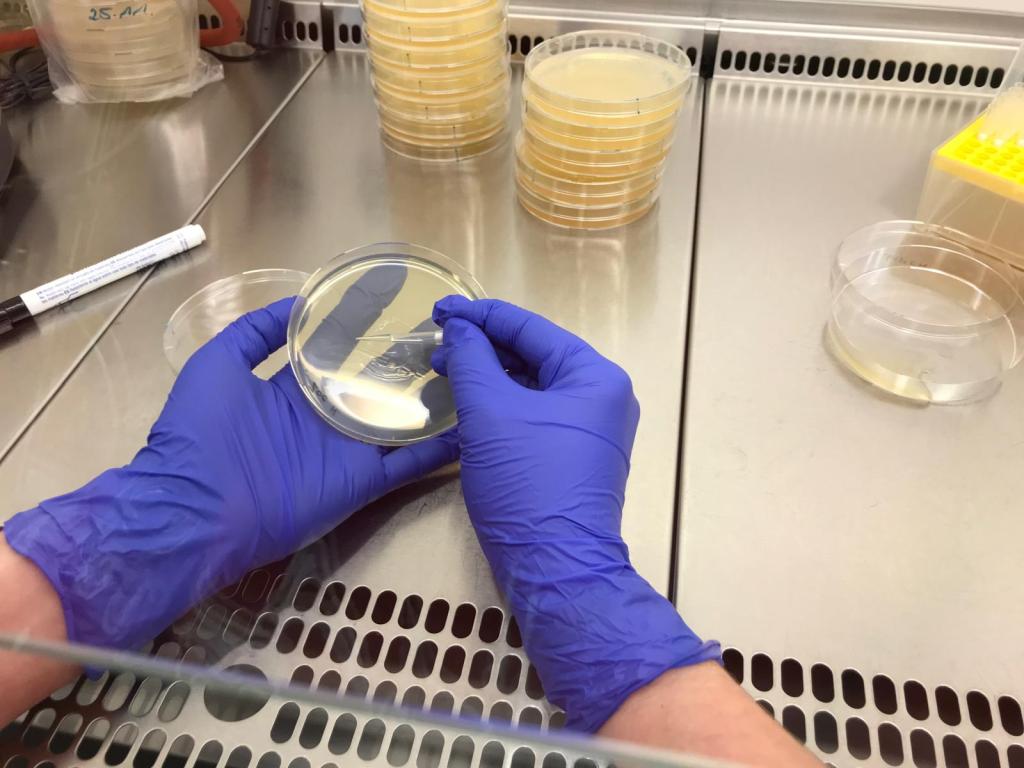

Naturwissenschaftlicher Zweig 6. Klasse (2022/2023) mit Markus Herbst


1. Workshop
Am 7. November haben wir (Alexandra, Johanna und Stefan) uns zu unserem allerersten Workshop im Projekt aufgemacht. Begleitet wurden wir von unserer ‚Instagram Beauftragten‘ Sabrina. Unser Ziel war das BORG Nonntal und die dortige 6. Klasse des naturwissenschaftlichen Zweiges. zum ganzen Beitrag

2. Workshop

Am 16. November waren wir (Alexandra, Johanna und Stefan) wieder am BORG Nonntal bei der 6c zu Gast. Zuerst einmal gab es einen Vortrag über Bakterien und ihre Bedeutung für die Ökosysteme und für uns. Die Schüler/innen wussten schon eine ganze Menge zum Thema, zum ganzen Beitrag
3. Die Gewässerproben
Die Schüler/innen hatten Proben von verschiedenen Gewässern mitgebracht, gefiltert und auf Agarplatten ausgestrichen. Nach zwei Wochen bei uns im Labor waren darauf einige interessante Kolonien gewachsen. Stefan hat eine Platte von jeder Schülerin und jedem Schüler fotografiert:
4. Die ersten Kulturen
Von den Agarplatten haben wir uns die Kolonien rausgesucht, die das typische ‚Aquirufa-Rot‘ zeigen. Von diesen haben wir mit einem (sterilisierten 😉 ) Zahnstocher ganz vorsichtig in ein bisschen flüssiges Medium gegeben. Dort konnten sich die Bakterienzellen weiter vermehren. Wenn die Flüssigkultur wieder das typische Rot aufwies, haben wir davon wieder ein wenig auf eine Agarplatte pipettiert und mit einer Impföse (das sind die langen Stäbe im 1. Bild) verteilt. Dabei streicht man die Kultur so aus, dass man flächiges Wachstum, aber auch einzelne Kolonien bekommt. Einige dieser Platten sehen schon jetzt sehr vielversprechend aus. Ein paar Fotos davon gibt es hier:
5. Auswahl der Kulturen
Im Labor haben sich nun eine ganze Menge Bakterienstämme angesammelt. Sie wachsen jetzt nicht nur auf Agarplatten, sondern auch in Flüssigkulturen. Die Kolben mit flüssigem Medium stehen auf einem Schüttler, wie das Foto zeigt. Hier werden die Bakterien leicht geschaukelt, damit sie genug Sauerstoff bekommen. Nun müssen wir die für unser Projekt interessanten Kulturen auswählen.

Dafür wird von jedem Bakterienstamm ein ganz kleiner Teil der Erbsubstanz analysiert. Dazu muss diese erstmal vervielfältigt werden. Das Verfahren nennt man PCR (Polymerasekettenreaktion). Für die Entwicklung dieser genialen Methode erhielt Karry Mullis 1993 den Nobelpreis für Chemie. Durchgeführt wird sie in einem sogenannten Thermocycler, wie im Bild zu sehen.

Zur Kontrolle werden dann alle erhaltenen Proben auf ein Gel aufgetragen und fotographiert. Die DNA-Proben werden verpackt, zur Post gebracht und nach Deutschland verschickt. Dort werden sie bei der Firma Eurofins sequenziert.

Man erhält nun für jede Probe eine ‚Sequenz‘ das ist nichts anderes als eine Abfolge der Buchstaben A, T, C und G. Für unseren GLASBACH-12 sieht das dann so aus: ein grüner Peak bedeutet A, ein roter T, ein schwarzer T und ein blauer C. Ein paar hundert Buchstaben bekommen wir so für jeden Stamm.

Nach der Analyse der Daten kam die große Überraschung für uns: von 16 von den Schüler/innen gesammelten Wasserproben haben wir aus 7 Proben Bakterienstämme von Aquirufa, das ist die Bakteriengattung, die wir untersuchen wollen, isolieren können. Das ist fast die Hälfte der Gewässer und hätten wir so nicht erwartet.

6. Die Aquirufa Gewässer
Aus diesen von den Schüler/innen selbstausgewählten Gewässern konnten wir von den im Klassenzimmer bearbeiteten Agarplatten Aquirufa Bakterienstämme isolieren: Leopoldskroner Weiher aus zwei Proben LEOWEIH-7 (Edna Jahija) und LEPPI-3 (Ioanna Polo), Wallersee (WALLSEE-11, Laura Kaltenbrunner), Fuschlsee (FUSSEE-8, Christina Rieger), ein namenloser Waldtümpel (WAEICH-18, Martin Windberger), Glasbach (GLASBACH-12, Mona Lechner) und Morzger Bach (MRZGBC-6, Nadine Pernsteiner).
Von sechs dieser Bakterienstämme werden wir das ganze Genom sequenzieren lassen, das bedeutet nicht wie bei der Vorauswahl ein paar hundert Buchstaben, sondern ca. 3 Millionen Buchstaben. Wir können schon mal verraten, aus welche Gewässern die Stämme sind: WALLSEE, LEOWEIH, LEPPI, FUSSEE (falls der Stamm kooperiert 😉 ) und WAEICH. Wir haben auch schon einen Verdacht, bei welchen es sich um eine neue Art handelt, aber um das sicher sagen zu können, brauchen wir die Aufschlüsselung des gesamten Genoms.

7. Analyse der Daten
Am 25.5. waren Alexandra und Stefan wieder im BORG Nonntal bei der 6c. Diesmal wurden am Computer die durch die Mitarbeit der Schüler/innen gewonnenen Daten analsiert. Von 7 Wasserproben hatten wir ja Aquirufa Stämme isolieren können. Aber auch in den anderen Gewässerproben konnten wir interessante Gewässerbakterien nachweisen. Mit Hilfe der zur Vorauswahl erhaltenen kurzen Sequenzabschnitte der Erbsubstanz und den von manchen Bakterienstämmen erhaltenen Genomsequenzen konnten die Schüler/innen die Aquirufa-Bakterienstämme selber zuordnen. MRZGB-6A und GLASBACH-12A gehören zur Art Aquirufa ecclesiirivi, WAEICH-18A zur Art Aquirufa autrantiipilula, im Fuschlsee konnten wir Aquirufa nivalisilvae nachweisen. Probleme bereitet hat uns die Probe aus dem Wallersee, da gab es Hinweise, dass hier zwei noch unbeschriebene Arten beheimatet sind, aber wir haben leider keine Bakterienstämme als Reinkultur bekommen. Aber am Wallersee bleiben wir auf alle Fälle dran 😉 . Die Stars des Tages waren LEPPI-3A und LEOWEIH-7C. Die beiden Bakterienstämme aus dem Leopoldskroner Weiher bilden gemeinsam eine neue Art, die wir nun mit Hilfe der Schüler/innen wissenschaftliche beschreiben werden und in einer internationalen Zeitschrift einen Artikel darüber veröffentlichen werden. Sandra Windisch hatte auch eine Probe aus dem Leopoldskroner Weiher gebracht, darin konnten wir die neue Art nicht finden. Aber sie hat uns ein Foto vom Weiher zur Verfügung gestellt, danke 🙂 
Die beiden Stämme aus dem Leopoldskroner Weiher werden nun zu zwei Stammsammlungen nach Japan und Deutschland geschickt. Dort werden sie aufbewahrt, damit sie jede/r Wissenschftler/in dort bestellen kann, um damit zu arbeiten. Ausserdem wird LEOWEIH-7C, der zum sogenannten Typstamm der neuen Art wird, zu unserem Kooperationspartner DSMZ nach Braunschweig geschickt. Dort werden weitere Analysen durchgeführt. Zum Verschicken haben wir LEOWEIH-7C gefriergetrocknet, hier kann man sehr schön das typische Aquirufa-Rot erkennen: 
Die Praktikantinnen werden im Sommer noch einige Experimente durchführen und Edna wird sich einen Namen überlegen. Auch für uns gibt es noch viel zu tun, bevor wir -hoffentlich- den gedruckten Artikel in Händen halten 😉 .
8. Sommerpraktikum von Anna, Lucie und Zoe
Bericht von Anna zum FFG Praktikum vom 10.7. – 2.8. 2023: In diesen vier vergangenen vier Wochen lernten zwei Mitschülerinnen und ich also einige Grundlagen der Laborarbeit…..hier geht es zum ganzen Bericht

9. Erste Publikation erschienen
Unsere erste wissenschaftliche Publikation im Projekt ist erschienen und hier verfügbar.
Sie enthält die Beschreibung einer neuen Bakterienart aus dem Leopoldskroner Weiher. Sie ist eine wirkliche Gemeinschaftsarbeit. Unsere Kooperationspartner von der DSMZ Braunschweig und den GUE Austria sowie Schülerinnen und Schüler vom BORG Nonntal, dem BG Vöcklabruck und dem BRG Schloss Wagrain haben mitgewirkt. Alle sind in der Danksagung namentlich erwähnt. Ganz ❤️ lichen Dank 😊.

10. Probenahme am Hellbrunner Bach und Almkanal
Unser letzter Besuch in diesem Schuljahr galt der 7. Klasse des naturwissenschaftlichen Zweiges des BORG Nonntals mit ihrem Lehrer Markus Herbst. Ziel war es Wasserproben für den zweiten Teil unseres Projektes zu sammeln. Daraus wollen wir später die DNA analysieren, um zu erfahren wie viele Aquirufa Arten es in unseren Gewässern nun wirklich gibt und welche Arten wo vorkommen. Stefan hatte schon 2 L Wasser aus dem Heimatgewässer von Aquirufa regiilacus, dem Leopoldskroner Weiher, geholt. Mit der Klasse machten wir uns noch zum Hellbrunner Bach und zum Almkamal auf. Mit unserem Teleskop Wasserschöpfer wurden Wasserproben genommen und Messungen durchgeführt. Besonderen Spaß machte das Messen der Fließgeschwindigkeit mit einem fluoreszierenden Tracer. Jetzt wünschen wir der Klasse einen schönen Sommer und freuen uns auf den Besuch bei uns im Forschungsinstitut im Herbst 😊.
11. Sommerpraktikum
Im August haben Zoe (BORG Nonntal) und Eleanor (HWL Neumarkt a.W.) bei uns im Institut in Mondsee ein Praktikum gemacht. Hier geht es zum Beitrag mit ihrem Bericht

12. Sommer in der Weitwörther Au

Probenahme in der Weitwörther Au mit unseren Praktikantinnen Zoe (BORG Nontal) und Eleanor (HBW Neumarkt a. W.). Vielleicht finden wir diesmal Aquirufa Bakterien, letzten Sommer hatten wir da nur in der Salzach Erfolg. zum Beitrag
13. Besuch in Mondsee
Im Januar 2025 war die Klasse mit ihrem Lehrer Markus Herbst bei uns in Mondsee zu Gast. Inzwischen sind die Schüler/innen in der 8. Klasse und werden bald Matura machen. Sie arbeiten schon seit fast 2,5 Jahren bei uns im Projekt mit und heute war unser letztes Treffen. Die Klasse hat mit Wasserproben, Beimpfen von Agarplatten und Mitarbeit im Rahmen von Sommer Praktika viel zum Projekt beigetragen. Eine wissenschaftliche Veröffentlichung ist dabei bereits herausgekommen und zwei weitere sind schon eingereicht. An Stationen wurde das Institut erkundet. Nur zur Beprobung am Mondsee war es zu kalt, dafür wurde das Bootshaus besichtigt. Zum Schluss gab es Partybrezeln. Die Klasse überreichte uns ein Geschenk und eine sehr liebe Karte. Die Pralinen werden unsere nächste Besprechung versüßen 🙂. Wir wünschen der Klasse alles Gute für die Matura!
14. Agarart
Hier sind die Kunstwerke der Klasse. Die Schüler/innen hatten bei ihrem Besuch bei uns auf Agarplatten mit Aquirufa Bakterien und Leuchtbakterien gemalt.
15. Publikation erschienen

Wie freuen uns sehr, dass unsere zweite wissenschaftliche Publikation im Projekt online erschienen ist. Untersucht haben wir dabei vier Gewässer im Renaturierungsgebiet der Weitwörther Au im Hinblick auf unsere Gewässerbakterien. Wir haben dabei zwei neue Arten entdeckt…hier gehts zum Beitrag
16. Wissenschaftliche Publikation erschienen
Unsere 3. wissenschaftliche Publikation ist erschienen und hier online verfügbar. Ca. 130 Citizen Scientists haben dabei mitgewirkt. Sechs Schulklassen und weitere Citizen Scientists haben Wasserproben aus selbst gewählten Gewässern genommen…hier gehts zum Beitrag

17. Sommerpraktikum Anna

Im Sommer 2025 waren zwei Schülerinnen bei uns im Labor für ein Praktikum zu Gast. Anna hat gerade am BORG Nonntal ihre Matura mit Auszeichnung bestanden und Eva wird ihren Abschluß nächstes Jahr am BRG Schloss Wagrain machen. Die Beiden waren sehr fleißig im Gelände und Labor, hier ist ihr Bericht: